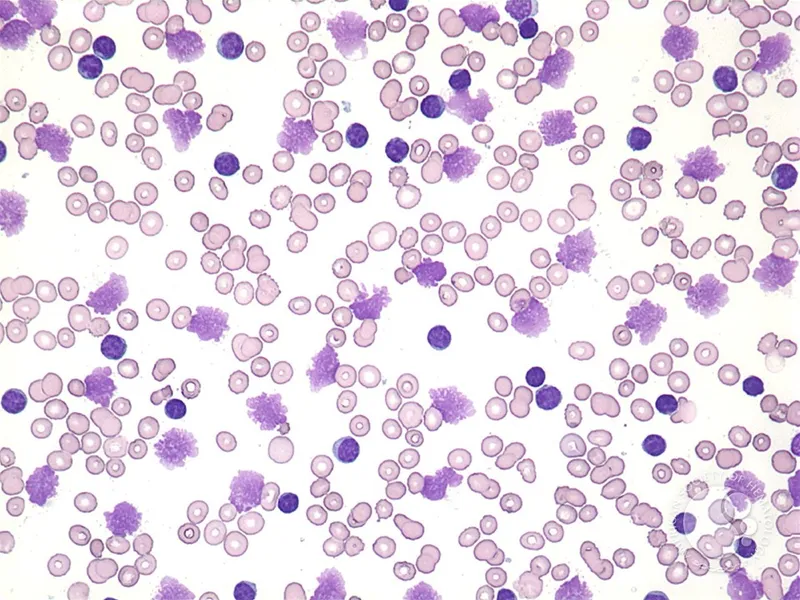
Figure 2: Blood film showing thrombocytopenia with large platelets

Quick Overview
Anticoagulant prescribing carries high risk of harm through bleeding or thrombosis. Safe use requires precise dosing based on renal function, systematic bleeding risk assessment, knowledge of reversal agents, and clear peri-procedural management. NICE NG196 emphasizes individualised therapy with regular monitoring and patient education.
Core Facts & Concepts
DOAC Dosing (Renal Adjustments)
| Drug | Standard Dose | CrCl 30-50 ml/min | CrCl 15-30 ml/min | CrCl <15 ml/min |
|---|---|---|---|---|
| Apixaban | 5mg BD | 2.5mg BD if ≥2 criteria* | 2.5mg BD | Avoid |
| Rivaroxaban | 20mg OD | 15mg OD | 15mg OD | Avoid |
| Edoxaban | 60mg OD | 30mg OD | 30mg OD | Avoid |
| Dabigatran | 150mg BD | 110mg BD | Avoid | Avoid |
*Apixaban dose reduction criteria: Age ≥80 years, weight ≤60kg, creatinine ≥133 µmol/L
Warfarin Target INR
- DVT/PE treatment: 2.5 (range 2.0-3.0)
- Recurrent VTE on warfarin: 3.5 (range 3.0-4.0)
- Mechanical heart valves: 2.5-3.5 (valve-dependent)

HAS-BLED Score (Bleeding Risk)
- Hypertension (SBP >160 mmHg): 1 point
- Abnormal renal/liver function: 1 point each
- Stroke history: 1 point
- Bleeding history/predisposition: 1 point
- Labile INR (TTR <60%): 1 point
- Elderly (age >65): 1 point
- Drugs/alcohol: 1 point each
Score ≥3 = HIGH RISK (requires closer monitoring, not contraindication)
Reversal Agents
- 💊 Warfarin: Vitamin K (IV 5-10mg) + Prothrombin Complex Concentrate (PCC) for major bleeding
- 💊 Dabigatran: Idarucizumab 5g IV (specific reversal)
- 💊 Xa inhibitors: Andexanet alfa 400-800mg IV OR PCC 50 units/kg
- 💊 All: Tranexamic acid 1g IV TDS as adjunct
⚠️ Warning: DOACs contraindicated in mechanical heart valves and antiphospholipid syndrome (warfarin only)
Problem-Solving Approach
Peri-Procedural Management (NICE NG196)
-
Classify bleeding risk of procedure
- Low risk: Continue anticoagulation (e.g., dental extraction, cataract surgery)
- High risk: Withhold anticoagulation (e.g., major surgery, spinal anaesthesia)
-
DOAC withholding times (high-risk procedures)
- CrCl ≥50: Omit 2 doses (BD drugs) or 24 hours (OD drugs)
- CrCl 30-50: Omit 3 doses (BD) or 48 hours (OD)
- CrCl 15-30: Omit 4 doses (BD) or 72 hours (OD)
-
Warfarin bridging (high thrombotic risk)
- Stop warfarin 5 days pre-procedure
- Check INR day before surgery (target <1.5)
- Bridge with therapeutic LMWH if high VTE/stroke risk
- Restart warfarin evening of surgery if haemostasis achieved
Major Bleeding Management
- Stop anticoagulant immediately
- ABC assessment, IV access, FBC/coagulation screen
- Give reversal agent (see above)
- Transfuse if Hb <70 g/L (target 70-90 g/L)
- Involve haematology/surgery urgently
🚩 Red Flags: INR >8, intracranial bleeding, uncontrolled bleeding despite measures, platelets <50×10⁹/L
Analysis Framework
DOAC vs Warfarin Comparison
| Feature | DOACs | Warfarin |
|---|---|---|
| Monitoring | None routine | Regular INR checks |
| Onset | 1-4 hours | 48-72 hours |
| Half-life | 8-15 hours | 36-48 hours |
| Renal excretion | 27-80% (drug-dependent) | Minimal |
| Food interactions | None | Vitamin K foods |
| Reversal | Specific/PCC | Vitamin K + PCC |
| Cost | Higher | Lower |
| Compliance monitoring | Difficult | INR tracking |
Critical Drug Interactions
- 🚫 Avoid with DOACs: Strong P-glycoprotein/CYP3A4 inhibitors (ketoconazole, dronedarone, verapamil)
- 🚫 Warfarin: Antibiotics (erythromycin, metronidazole), amiodarone, NSAIDs ↑ INR
- ⚠️ Antiplatelet + anticoagulant: Only if clear indication (e.g., ACS + AF) - increases bleeding risk 2-3 fold
Visual Aid
Renal Function Assessment
- Calculate CrCl using Cockcroft-Gault equation for DOAC dosing
- Recheck renal function annually (every 6 months if CrCl <60 ml/min)
- Acute illness: Reassess renal function immediately
Key Points Summary
✓ HAS-BLED ≥3 = high bleeding risk requiring closer monitoring, NOT a contraindication to anticoagulation
✓ DOAC dosing: Reduce when CrCl <50 ml/min; avoid if <15 ml/min (apixaban/rivaroxaban 15-30 ml/min acceptable)
✓ Peri-procedural: Withhold DOACs for 2-4 doses depending on renal function; warfarin needs 5 days + INR <1.5
✓ Reversal agents: Idarucizumab for dabigatran, andexanet alfa/PCC for Xa inhibitors, vitamin K + PCC for warfarin
✓ Major bleeding: Stop drug, give reversal agent, transfuse if Hb <70 g/L, involve specialists urgently
✓ Avoid DOACs in mechanical valves, antiphospholipid syndrome, and with strong P-gp/CYP3A4 inhibitors
✓ Annual renal monitoring mandatory for DOACs; more frequent if CrCl <60 ml/min or acute illness